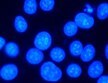

トランスフェクション試薬の製品 & 特長 - Roche®製品
20年以上にわたって、トランスフェクション技術を向上させ続けてきたロシュのX-tremeGENE®は、細胞毒性の低さに起因する信頼性と(遺伝子導入が難しいとされる細胞も含め)広範な細胞種に対するトランスフェクション効率において、優れた性能を発揮します。 導入効率、簡易な用法、データの再現性により、生体内に近い状態での実験を可能にします。

おすすめ製品 X-tremeGENE® 360 トランスフェクション試薬
DNA やRNA およびCRISPR/Cas9 タンパク質のすべてをトランスフェクションできる トランスフェクション試薬「X-tremeGENE® 360」 が誕生しました。

X-tremeGENE® HP DNA Transfection Reagent
昆虫細胞や一般的に導入が困難とされる細胞種など、広範な真核細胞に使用できます。 X-tremeGENE® HPは、動物由来の成分を不使用、フィルター濾過(0.2 µm)滅菌済かつ、血清存在下でも使用できるノン リポソーマル試薬です。細胞に与えるダメージは必要最低限に抑えながらも、DNAの導入効率はひときわ高く保たれています。

X-tremeGENE® 9 DNA Transfection Reagent
汎用的なセル ライン種での細胞解析に適した、ノン リポソーマル試薬です。 細胞毒性が極めて低く、細胞に与える悪影響が少ないため、実験条件を最短時間で至適化できます。 低い細胞濃度や血清存在下でも使用できるのもX-tremeGENE® 9の特長です。
X-tremeGENE® siRNA Transfection Reagent
HeLa、NIH 3T3、HEK-293、CHO-K1、COS-7などの汎用的な細胞、あるいはトランスフェクションが困難な細胞にもsiRNAを効率的に導入します。CotransfectionをベースとするRNAiに使用した場合,高いトランスフェクション効率により,本試薬は顕著なタンパク質発現と効率的なノックダウンレベルを両立させます。

負に帯電した分子を、カチオンリポソームを介して真核細胞中に導入するリポフェクション試薬です。in vivoを含む多様なアプリケーションで実績があり、導入できる分子の多様性(DNA、RNA、オリゴヌクレオチド、ヌクレオチド、RNP複合体など)においても高い評価を得ています。
関連製品群
ロシュは、高純度での核酸調製から簡便な機能アッセイまで、トランスフェクション実験のすべての過程で研究を支援する製品群を提供しています。
選択用抗生物質
Transientなトランスフェクションとは、プラスミドDNAをRNA転写におけるごく暫時的なテンプレートとして利用する、一時的なトランスフェクションです。 これに対してstableなトランスフェクションとは、host cellへの外部プラスミドDNAの導入と、安定的な形質転換体の生成を指します。 これらDNAが導入された細胞と、それ以外の細胞とは厳密に分離・選択されるのが理想的です。
このステップにおいてもっとも一般的な手法は、抗生物質耐性を安定的に発現している細胞の選択です。 現実的には、プラスミドに目的遺伝子だけでなく抗生物質耐性遺伝子を含ませるか、耐性遺伝子のみを有する別のプラスミドを同時にトランスフェクションすることになります。
テンプレートの精製
多くの分子細胞学実験、および全ての組換DNA手技の第一段階は、核酸の調製です。 標準的な核酸抽出・精製プロセスは、時間がかかる、有害薬物の操作あるいは(超遠心等)高額機器を必要とする、といった欠点を抱えていました。
Reporter Geneアッセイ
ロシュは、トランスフェクション細胞でのreporter geneアッセイ用non-RI試薬およびキットを、幅広くそろえています。 RI実験レベルと同等以上の感度を実現した安全なアッセイのキットは、クロラムフェニコール アセチル トランスフェラーゼ(CAT)、ß-galactosidase (ß-gal)、luciferase (Luc)、分泌型アルカリ ホスファターゼ(SEAP)、ヒト成長ホルモン(hGH)によって解析されます。
Gene Regulationアッセイ
RNA転写およびpromoter解析を含む遺伝子発現解析ラインアップは、下記の製品群をご参照ください。
X-tremeGENE is a registered trademark of Roche.
続きを確認するには、ログインするか、新規登録が必要です。
アカウントをお持ちではありませんか?